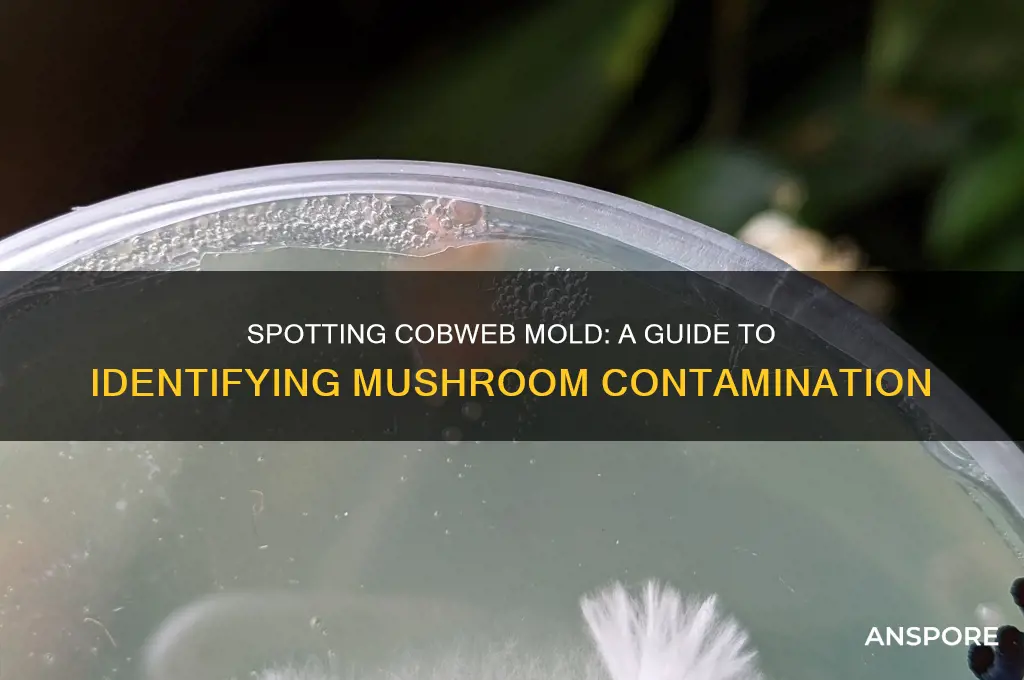
how to identify cobweb mold on mushrooms

Cobweb mold, a common fungal pathogen, poses a significant threat to mushroom cultivation, making early identification crucial for preventing widespread contamination. This mold, scientifically known as *Hypomyces* or *Cladobotryum*, manifests as a white, fluffy, or cobweb-like growth that rapidly spreads across mushroom substrates, mycelium, and fruiting bodies. Unlike beneficial mycelium, cobweb mold appears more delicate and often has a distinct, wispy texture, sometimes accompanied by yellow, green, or black spores as it matures. Recognizing these early signs—such as a fine, thread-like network or a cottony appearance—is essential for distinguishing it from healthy mycelium and taking immediate action to isolate and eradicate the infestation, thereby safeguarding the mushroom crop.
| Characteristics | Values |
|---|---|
| Appearance | Fine, white, cobweb-like filaments spreading across the substrate or mushrooms. |
| Texture | Delicate, thread-like, and easily disturbed. |
| Color | Initially white, may turn grayish or greenish as it matures or sporulates. |
| Growth Pattern | Rapidly spreads in a web-like manner, often covering large areas. |
| Location | Found on the surface of mushrooms, substrate, or casing layer. |
| Sporulation | Produces spores that may appear as a dusty or powdery coating. |
| Smell | Typically odorless, though some strains may have a faint musty scent. |
| Impact on Mushrooms | Inhibits mushroom growth, causes stunted or deformed fruiting bodies. |
| Environmental Conditions | Thrives in high humidity (above 85%) and moderate temperatures (20-28°C). |
| Prevention | Maintain proper ventilation, hygiene, and humidity control. |
| Common Species | Mucor, Rhizopus, and other Zygomycota fungi. |
| Distinction from Mycelium | Cobweb mold is finer, more uniform, and spreads rapidly compared to mycelium. |
| Treatment | Remove affected areas, improve conditions, and use fungicides if necessary. |
Explore related products
What You'll Learn
- Visual Signs: White, fuzzy patches spreading rapidly across mushroom surfaces, often with cobweb-like strands
- Texture Changes: Mushrooms become slimy or stringy due to mold growth, losing firmness
- Color Variations: Initial white mold may turn yellow, green, or brown as it matures
- Smell Indicators: Musty or sour odor signals cobweb mold contamination in mushroom colonies
- Growth Patterns: Mold spreads quickly, covering mushrooms and substrate in a web-like network

Visual Signs: White, fuzzy patches spreading rapidly across mushroom surfaces, often with cobweb-like strands
Cobweb mold, a common contaminant in mushroom cultivation, is easily identifiable through its distinctive visual signs. One of the most prominent indicators is the appearance of white, fuzzy patches on the mushroom surfaces. These patches are not merely superficial but often spread rapidly, engulfing large areas of the mushrooms within a short period. The texture of these patches is notably fuzzy, resembling the fine, downy growth of mold rather than the smooth or structured surfaces of healthy mushrooms. This fuzziness is a key characteristic that distinguishes cobweb mold from other types of contamination.
As the cobweb mold progresses, it begins to develop cobweb-like strands that interconnect the fuzzy patches. These strands are thin, delicate, and often translucent, giving them a spiderweb-like appearance. They can stretch across the mushrooms, connecting different areas of mold growth, and may even extend to nearby substrates or surfaces. The presence of these strands is a strong visual cue that the contamination is indeed cobweb mold, as few other molds produce such a distinctive network of filaments. Observing these strands under proper lighting can make them more apparent, especially when they contrast against the darker substrate or mushroom tissue.
The rapid spread of cobweb mold is another critical visual sign to watch for. Unlike some molds that grow slowly, cobweb mold can colonize mushrooms at an alarming rate, often doubling in size within 24 hours under favorable conditions. This rapid growth is accompanied by the expansion of both the fuzzy patches and the cobweb-like strands. Cultivators should monitor their mushrooms closely, as early detection is crucial for preventing the mold from overtaking the entire crop. If left unchecked, the mold can completely cover the mushrooms, rendering them unusable and potentially spreading to other areas of the growing environment.
To identify cobweb mold accurately, it is essential to examine the mushrooms under good lighting and from multiple angles. The white color of the mold is typically consistent, though it may appear slightly off-white or creamy in certain conditions. The fuzzy texture and cobweb-like strands are best observed up close, as they may not be immediately visible from a distance. Using a magnifying glass or taking a close-up photo can aid in confirming the diagnosis. Additionally, the mold’s growth pattern—spreading outward in a radial or interconnected manner—further reinforces its identification as cobweb mold.
Lastly, it is important to differentiate cobweb mold from other types of mold or mushroom growth. For instance, mycelium—the vegetative part of a fungus—can sometimes appear fuzzy but lacks the cobweb-like strands and does not spread as rapidly. Other molds may produce colored patches (e.g., green, black, or blue) rather than the characteristic white of cobweb mold. By focusing on the visual signs of white, fuzzy patches with cobweb-like strands and their rapid spread, cultivators can confidently identify cobweb mold and take appropriate measures to mitigate its impact.
Freezing Psychedelic Mushrooms: Best Storage Method or Risky Move?
You may want to see also

Texture Changes: Mushrooms become slimy or stringy due to mold growth, losing firmness
Cobweb mold on mushrooms is often first noticeable through significant texture changes, particularly the transformation from a firm, fleshy structure to a slimy or stringy surface. Healthy mushrooms typically have a smooth, slightly moist exterior with a resilient texture. However, when cobweb mold takes hold, the mushroom’s surface becomes unnaturally wet and slippery, indicating the presence of mold spores and their associated mycelium. This sliminess is a direct result of the mold’s growth, which secretes enzymes that break down the mushroom’s cell walls, releasing moisture and altering its texture.
As cobweb mold progresses, the sliminess may give way to a stringy or fibrous feel. This occurs because the mold’s mycelium forms a network of thread-like structures across the mushroom’s surface. When touched, the mushroom may feel sticky or tangled, almost as if fine threads are clinging to your fingers. This stringy texture is a clear sign of advanced mold growth, as the mycelium spreads and colonizes the mushroom’s tissues. At this stage, the mushroom’s original firmness is completely lost, and it becomes structurally weak and prone to disintegration.
To identify these texture changes, gently press or touch the mushroom’s surface. If it feels unusually wet, sticky, or fibrous, cobweb mold is likely present. Compare the affected mushroom to a healthy one to notice the stark difference in texture. Healthy mushrooms should feel plump and slightly springy, while mold-infected mushrooms will feel soft, mushy, or stringy. The loss of firmness is a critical indicator, as it signals that the mushroom’s internal structure has been compromised by the mold’s activity.
Another way to assess texture changes is by observing how the mushroom reacts to handling. A healthy mushroom will retain its shape when lightly squeezed, whereas a mold-infected mushroom may collapse or leave a slimy residue on your fingers. The stringy texture may also be visible to the naked eye, appearing as a fine, web-like layer covering the mushroom’s surface. This visual and tactile combination is a definitive sign of cobweb mold infestation.
Preventing texture changes due to cobweb mold involves maintaining proper growing conditions, such as adequate airflow, humidity control, and cleanliness. Regularly inspect mushrooms for early signs of sliminess or stringiness, as catching the mold in its initial stages can prevent further spread. Once texture changes are evident, the affected mushrooms should be removed immediately to protect the rest of the crop. Understanding these texture changes is essential for early identification and management of cobweb mold in mushroom cultivation.
Can Dogs Eat Cream of Mushroom Soup? Safety Tips Revealed
You may want to see also

Color Variations: Initial white mold may turn yellow, green, or brown as it matures
Cobweb mold, a common contaminant in mushroom cultivation, often begins as a fine, white, thread-like growth that resembles a spider’s web. This initial white appearance is a key indicator of its early stages. However, as cobweb mold matures, it undergoes noticeable color changes that can help cultivators identify and address the issue promptly. Understanding these color variations is crucial, as they signal the progression of the mold and its potential to spread rapidly, jeopardizing the entire mushroom crop.
The first color shift typically occurs when the white mold begins to turn yellow. This yellowing is a sign that the mold is actively growing and colonizing the substrate or mushrooms. At this stage, the mold’s threads become more visible and may appear denser. Cultivators should take immediate action upon noticing this change, as yellow cobweb mold indicates an advancing infestation. Proper ventilation, humidity control, and removal of affected areas can help mitigate further spread.
As the mold continues to mature, it may progress to a green hue. Green cobweb mold is often associated with the presence of spores, which are the mold’s reproductive structures. This stage is particularly concerning, as the spores can disperse easily, contaminating other areas of the grow space. The green color is usually more intense and may appear patchy or uneven. At this point, the mold is highly developed, and salvaging the affected mushrooms becomes increasingly difficult. Immediate isolation and disposal of contaminated materials are essential to prevent further contamination.
In some cases, cobweb mold may also turn brown as it ages. Brown mold often indicates that the mold is beginning to degrade or that environmental conditions are less favorable for its growth. However, this does not mean the threat is over; brown mold can still produce spores and spread. The brown color may appear dull or dark, and the mold’s texture might become more brittle. Cultivators should remain vigilant and continue to monitor the grow area, as even dormant or degraded mold can pose a risk under the right conditions.
Observing these color variations—from white to yellow, green, or brown—is a practical way to track the lifecycle of cobweb mold on mushrooms. Early detection, particularly during the white or yellow stages, offers the best chance of controlling the mold before it becomes unmanageable. Regular inspection, maintaining optimal growing conditions, and practicing good hygiene in the cultivation space are key strategies to prevent and manage cobweb mold effectively. By staying informed about these color changes, cultivators can protect their mushroom crops and ensure a healthier harvest.
Mushroom Legality in Ireland: What's the Deal?
You may want to see also
Explore related products

Smell Indicators: Musty or sour odor signals cobweb mold contamination in mushroom colonies
One of the most reliable ways to identify cobweb mold contamination in mushroom colonies is by paying close attention to smell indicators. Cobweb mold, a common fungal contaminant, often produces a distinct musty or sour odor that can alert cultivators to its presence even before visual signs become apparent. This odor is a result of the mold’s metabolic processes as it colonizes the substrate or mushrooms. When inspecting your mushroom grow area, take a moment to deeply inhale near the colonies. A healthy mushroom environment typically has a fresh, earthy scent, whereas the presence of cobweb mold introduces an off-putting, pungent smell that is difficult to ignore.
The musty odor associated with cobweb mold is often described as resembling damp wood or old basement smells. This is because the mold releases volatile organic compounds (VOCs) as it grows, which contribute to the characteristic aroma. If you notice this smell, it’s crucial to act quickly, as cobweb mold can spread rapidly and jeopardize the entire crop. The sour component of the odor can be likened to fermented fruit or spoiled food, which further distinguishes it from the natural scent of mushrooms. Cultivators should train themselves to recognize these specific olfactory cues as early warning signs of contamination.
To effectively use smell indicators, ensure your grow area is well-ventilated, as poor air circulation can trap odors and make detection more challenging. Regularly sniffing around the substrate, mycelium, and fruiting mushrooms can help you establish a baseline for what a healthy grow smells like, making it easier to identify deviations. If you detect a musty or sour odor, immediately inspect the area for visible signs of cobweb mold, such as white, fuzzy patches resembling spider webs. Combining olfactory detection with visual inspection increases the accuracy of identifying contamination early.
It’s important to note that while smell indicators are highly effective, they should not be solely relied upon. Cobweb mold in its early stages may not produce a strong odor, especially in small or contained environments. Therefore, cultivators should also monitor humidity levels, maintain proper hygiene, and regularly inspect their colonies for any abnormalities. However, once the musty or sour smell becomes noticeable, it’s a clear signal that cobweb mold has established itself and requires immediate intervention to prevent further spread.
In summary, the musty or sour odor associated with cobweb mold is a critical smell indicator that cultivators must be vigilant about. This odor is a direct result of the mold’s growth and can serve as an early warning system for contamination. By familiarizing yourself with the scent and regularly monitoring your grow area, you can take proactive steps to protect your mushroom colonies. Remember, early detection through smell indicators, combined with visual inspection and environmental control, is key to managing cobweb mold effectively.
Happie Mushrooms: Legit or a Scam?
You may want to see also

Growth Patterns: Mold spreads quickly, covering mushrooms and substrate in a web-like network
Cobweb mold, a common contaminant in mushroom cultivation, is notorious for its rapid and invasive growth patterns. One of the most distinctive features of cobweb mold is its ability to spread quickly, forming a web-like network that envelops both the mushrooms and the substrate. This growth pattern is often likened to a spider’s web, with thin, white, or grayish strands that intertwine and expand aggressively. The mold’s hyphae, which are the thread-like structures of the fungus, grow in all directions, creating a dense, cobweb-like mat that can smother the mushrooms within a matter of days if left unchecked.
The initial stages of cobweb mold growth may appear as small, localized patches of fuzzy, white material on the substrate or mushroom surface. However, these patches rapidly expand, merging with other areas of growth to form a continuous network. This web-like structure is not only visually striking but also highly efficient in colonizing the available space. The mold’s ability to spread quickly is due to its fast-growing hyphae, which can outcompete the mushroom mycelium for nutrients and space. As the mold spreads, it depletes resources and blocks light, hindering the mushrooms' growth and development.
Observing the substrate is crucial for identifying the spread of cobweb mold. The mold often begins at the edges of the growing container or where the substrate is most exposed. From there, it extends its web-like network inward, covering the entire surface and penetrating deeper layers of the substrate. This invasive growth can be particularly damaging in bulk substrates or grain spawn, where the mold’s hyphae can quickly colonize the entire medium, rendering it unusable for mushroom cultivation. The substrate may also appear discolored or waterlogged in areas heavily infested with cobweb mold.
On the mushrooms themselves, cobweb mold manifests as a delicate, white or grayish web that drapes over the caps, stems, and even the gills. This webbing can start as a thin layer but thickens as the mold continues to grow, eventually enveloping the entire mushroom. Affected mushrooms often become distorted, stunted, or fail to develop properly due to the mold’s suffocating presence. In advanced cases, the mushrooms may collapse or rot beneath the mold’s dense network, leading to significant crop loss.
To effectively identify and manage cobweb mold, cultivators must monitor their grow environments closely, especially during the early stages of mushroom development. The mold thrives in high-humidity conditions and can exploit any weakness in the substrate or growing conditions. Regular inspection for the characteristic web-like growth patterns is essential, as early detection allows for prompt intervention, such as removing affected areas or improving air circulation. Understanding the rapid and invasive growth patterns of cobweb mold is key to protecting mushroom crops and maintaining a healthy cultivation environment.
Exploring Mushroom Genetics: Do Mushrooms Have Two Haploid Nuclei?
You may want to see also
Frequently asked questions
Cobweb mold appears as a white, fuzzy, or cobweb-like growth on the surface of mushrooms, often spreading rapidly and resembling spider webs or cotton.
Cobweb mold is typically whiter, more stringy, and spreads across the surface, while mycelium is usually denser, less web-like, and grows from the substrate or mushroom base.
Cobweb mold often has a faint musty or earthy odor, but it’s less pronounced compared to other contaminants like bacteria, which may smell foul or ammonia-like.
Cobweb mold is usually white, but in advanced stages, it may turn slightly yellow or green due to spore production or secondary contamination.
Cobweb mold can spread rapidly, often within 24–48 hours under favorable conditions (high humidity and warmth), covering large areas of the mushroom or substrate.











































